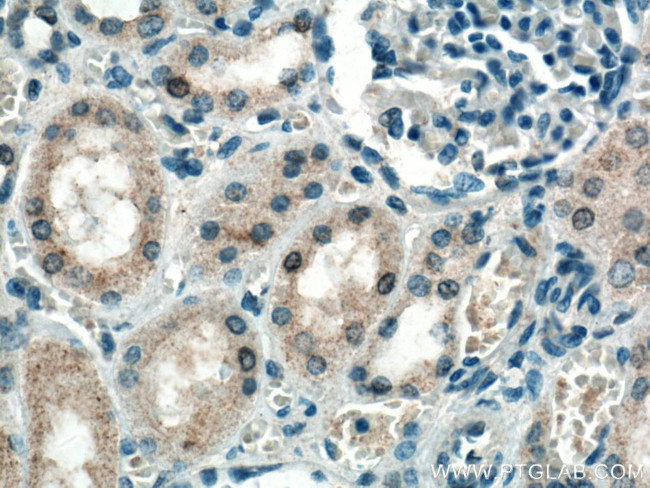
EIF2AK2 Antibody in Immunohistochemistry (Paraffin) (IHC (P))

Search
Proteintech
EIF2AK2 Monoclonal Antibody (2A8A4)
{{$productOrderCtrl.translations['antibody.pdp.commerceCard.promotion.promotions']}}
{{$productOrderCtrl.translations['antibody.pdp.commerceCard.promotion.viewpromo']}}
{{$productOrderCtrl.translations['antibody.pdp.commerceCard.promotion.promocode']}}: {{promo.promoCode}} {{promo.promoTitle}} {{promo.promoDescription}}. {{$productOrderCtrl.translations['antibody.pdp.commerceCard.promotion.learnmore']}}
产品信息
66646-1-IG
种属反应
宿主/亚型
分类
类型
克隆号
抗原
偶联物
形式
浓度
规格
纯化类型
保存液
内含物
保存条件
运输条件
产品详细信息
This antibody is specific to EIF2AK2.
Immunogen sequence: MAGDLSAGF FMEELNTYRQ KQGVVLKYQE LPNSGPPHDR RFTFQVIIDG REFPEGEGRS KKEAKNAAAK LAVEILNKEK KAVSPLLLTT TNSSEGLSMG NYIGLINRIA QKKRLTVNYE QCASGVHGPE GFHYKCKMGQ KEYSIGTGST KQEAKQLAAK LAYLQILSEE TSVKSDYLSS GSFATTCESQ SNSLVTSTLA SESSSEGDFS ADTSEINSNS DSLNSSSLLM NGLRNNQRKA KRSLAPRFDL PDMKETKYTV DKRFGMDFKE IELIGSGGFG QVFKAKHRID GKTYVIKRVK YNNEKAEREV KALAKLDHVN IVHYNGCWDG FDYDPETSDD SLESSDYDPE NSKNSSRSKT KCLFIQMEFC DKGT (1-373 aa encoded by BC093676)
靶标信息
EIF2AK2 (PKR) is one of 4 kinases that specifically phosphorylate Ser51 of translation initiation factor eIF2-alpha in response to various environmental stresses. EIF2AK2 plays a key role in antiviral defense mediated through its direct activation by double-stranded RNA produced by viral infection. PKR plays a key role in IFN induced-innate antiviral response, virus-induced apoptosis, cell growth & differentiation. PKR induces apoptosis by up-regulating Fas expression and mediates FADD/Caspase-8 death signaling pathway. Upon viral infection, it functions as a dual protein, sequentially activating both cell survival & cell death pathways using kinase independent and dependent strategies. PRKR regulates multiple pathways which include NF-kappaB activation, p53, p38, & PDGF signaling pathway. PKR has been implicated in tumor suppression & malignancy. To evade the antiviral effects of PKR, viruses have evolved multiple mechanisms, such as the inhibition of PKR by the non-structural protein (NS1) of the influenza virus. More recently, PKR has been implicated in several neurodegenerative diseases including Alzheimer, Huntington, and amyotrophic lateral sclerosis.
仅用于科研。不用于诊断过程。未经明确授权不得转售。
篇参考文献 (0)
生物信息学
蛋白别名: double stranded RNA activated protein kinase; EC 2.7.11.1; eIF-2A protein kinase 2; eIF2a Kinase; Eukaryotic translation initiation factor 2-alpha kinase 2; Interferon-induced, double-stranded RNA-activated protein kinase; interferon-inducible elF2alpha kinase; Interferon-inducible RNA-dependent protein kinase; MGC126524; OTTHUMP00000201320; P1/eIF-2A protein kinase; p68 kinase; PKR; PRKR; protein kinase R; Protein kinase RNA-activated; protein kinase RNA-regulated; protein kinase, interferon-inducible double stranded RNA dependent; protein phosphatase 1, regulatory subunit 83; Tyrosine-protein kinase EIF2AK2; unnamed protein product
基因别名: DYT33; EIF2AK1; EIF2AK2; LEUDEN; PKR; PPP1R83; PRKR
UniProt ID: (Human) P19525
Entrez Gene ID: (Human) 5610